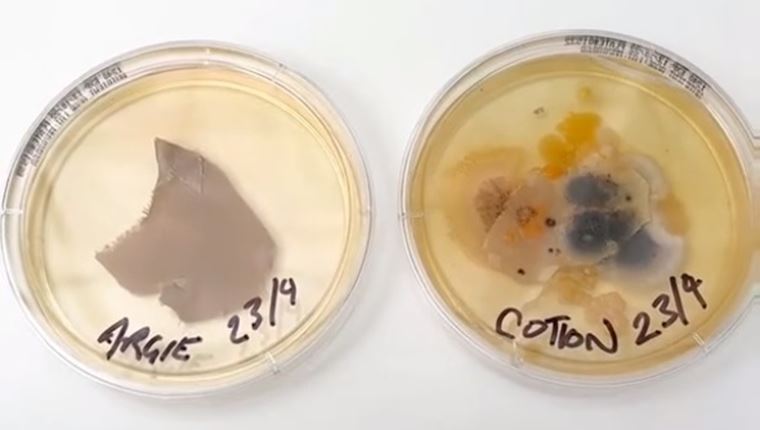
Άπλυτη μαξιλαροθήκη vs κάθισμα τουαλέτας: Πού κατοικούν περισσότερα βακτήρια;

Stop the press, κυκλοφορεί χάπι για το hangover
Είναι ακόμα σε πειραματικό στάδιο όσον αφορά στην αποδοτικότητά του, ωστόσο στο Ηνωμένο Βασίλειο ξεκίνησε να πωλείται.
Γραφει Τιμος ΣαλαμεςΛίγο Ashwaganda την ημέρα, το χρόνιο στρες κάνει πέρα
Βρίσκεται σε όλων των ειδών τα συμπληρώματα, αλλά μπορεί να έχει διαφύγει της προσοχής σου. Μέχρι τώρα.
Γραφει Τιμος ΣαλαμεςΤο βιογραφικό του Bill Gates πριν από 49 χρόνια είναι τόσο εντυπωσιακό όσο φαντάζεσαι
Στα 18 του, πρωτοετής φοιτητής του Harvard, έφτιαξε ένα βιογραφικό που τα είχε όλα.
Γραφει Τιμος ΣαλαμεςΚι αν αυτό είναι το καλοκαίρι του τριχωτού άντρα;
Η ζωή γίνεται λίγο πιο εύκολη για όλους εμάς που μεγαλώσαμε τριχωτοί σε μια εποχή που όλοι ξύριζαν το στέρνο τους.
Γραφει Τιμος ΣαλαμεςΕύκολο καλοκαιρινό office look σε 5 βήματα
Από το λινό πουκάμισο μέχρι το backpack που θα βάλεις το laptop σου, τα πάντα μπορεί να φωνάζουν ότι είσαι επαγγελματίας.
Γραφει Τιμος ΣαλαμεςΜία μέρα στη θάλασσα για να γίνεις καλύτερος
Λίγο ο ήλιος, λίγο η αμμουδιά και το θαλασσινό αλάτι και έχεις το free spa που σου αξίζει.
Γραφει Τιμος ΣαλαμεςΆπλυτη μαξιλαροθήκη vs κάθισμα τουαλέτας: Πού κατοικούν περισσότερα βακτήρια;
Ένα βίντεο στο TikTok μας βάζει σε υπερβολικά πολλές σκέψεις.
Γραφει Τιμος Σαλαμες10 πράγματα που δε γνωρίζεις για την Camila Mendes
Η πρωταγωνίστρια του Riverdale κλείνει σήμερα τα 29.
Γραφει Τιμος ΣαλαμεςΌσα πρέπει να γνωρίζεις για την επιστροφή του Indiana Jones στους κινηματογράφους
"Ο Ιndiana Jones και ο δίσκος του πεπρωμένου" κυκλοφορεί στις 29 Ιουνίου.
Γραφει Τιμος ΣαλαμεςΧτίζοντας τεράστια δύναμη με ένα λάστιχο αντίστασης
3 supersets για μυϊκή υπερφόρτωση, που μπορείς να εκτελέσεις άνετα στο γυμναστήριο, στο σπίτι ή στην παραλία.
Γραφει Τιμος ΣαλαμεςJack Harlow, ο πιο καλοντυμένος ράπερ εκεί έξω
Ο Jack Harlow έχει το δικό του στυλ και για κάποιους εκεί έξω, αποτελεί έμπνευση.
Γραφει Τιμος ΣαλαμεςTα ηλεκτρικά οχήματα και η επίδρασή τους στο δίκτυο ηλεκτρικής ενέργειας
Υπάρχουν πολλές μεταβλητές που πρέπει να εξετάζουμε όταν μιλάμε για την ηλεκτροκίνηση.
Γραφει Τιμος ΣαλαμεςΟ άπιστος Neymar απολογείται στη Bruna Biancardi
O Neymar απάτησε τη γυναίκα του ενώ είναι έγκυος και απολογήθηκε δημόσια: "Συγγνώμη, η αγάπη μας για το μωρό μας θα νικήσει".
Γραφει Τιμος Σαλαμες